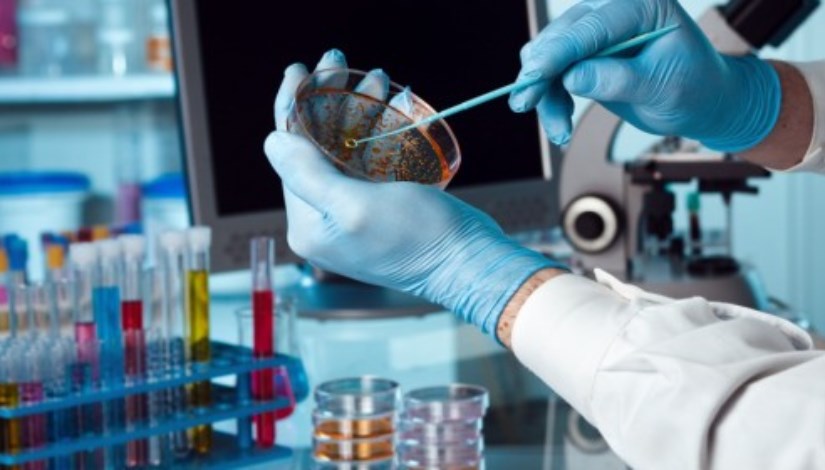

27 أكتوبر، آخر موعد للحصول على كوبون العربية للأدوية بـ8 جنيهات
الأربعاء، 15 أكتوبر 2025 10:28 ص
الصناعات الكيماوية
أعلنت الشركة العربية للأدوية والصناعات الكيماوية، المدرجة في البورصة المصرية، اليوم الأربعاء الموافق 15-10-2025، موعد نهاية الحق في الحصول على توزيع الكوبون النقدي بواقع 8.333 جنيهًا للسهم، في 27 أكتوبر 2025.
وقالت الشركة في الإفصاح المرسل للبورصة، اليوم الأربعاء، إنه سيتم صرف الكوبون رقم (28) في 30 أكتوبر 2025، بواقع 8.333 جنيهًا للسهم، وتتولى جهة التنفيذ شركة مصر للمقاصة والإيداع والقيد المركزي.

_1768_102713.jpg)
أرباح العربية للأدوية والصناعات الكيماوية
أوضحت الشركة في الإفصاح المرسل للبورصة، في وقت سابق، تسجيل 227.85 مليون جنيه، خلال أول 6 أشهر من 2025، مقابل أرباح بقيمة 102.8 مليون جنيه عن الفترة من يناير وحتى نهاية يونيو 2024.
مبيعات العربية للأدوية والصناعات الكيماوية
وارتفعت مبيعات الشركة لتسجل 1.115 مليار جنيه، خلال الفترة من يناير وحتى نهاية يونيو، مقابل أرباح بقيمة 784.6 مليون جنيه عن أول 6 أشهر من 2024.
اقرأ أيضًا:
بزيادة 77%، أرباح «بنك التعمير والإسكان» تقفز لـ4.95 مليارات جنيه في 90 يومًا
البنك المصري لتنمية الصادرات يحقق أرباحًا بـ1.35 مليار جنيه في 3 أشهر
إيقاف التداول على أسهم «مطاحن مصر الوسطى»، والبورصة توضح
تابع موقع إيجي إن عبر تطبيق (نبض) اضغط هــــــــنا
تابع موقع إيجي إن عبر تطبيق (تليجرام) اضغط هــــــــنا
تابع موقع إيجي إن عبر قناة (يوتيوب) اضغط هــــــــنا
تابع موقع إيجي إن عبر تطبيق (واتساب) اضغط هــــــــن
إيجي إن-Egyin، هو موقع متخصص في الصناعة والاقتصاد، ويهتم بتقديم خدمة صحفية متميزة للقارئ، وهدفنا أن نصل لقرائنا الأعزاء بالخبر الأدق والأسرع والحصري، إضافة للتغطية والمتابعة على مدار الـ24 ساعة، لـ"أسعار الذهب، أسعار العملات، أسعار السيارات، أسعار المواد البترولية"، في مصر والوطن العربي وحول العالم.
Short Url
محافظ الجيزة يتفقد مصنع الجود لإنتاج وتعبئة التمور وزيت الزيتون بالواحات البحرية
15 أكتوبر 2025 07:55 م
بفترة سداد 10 سنوات، تفاصيل قرض المشروعات الصغيرة بفائدة مميزة
15 أكتوبر 2025 03:59 م
بـ15 ملايين دولار، «اقتصادية السويس» توقع مشروعًا جديدًا لصناعة المنسوجات بالسخنة
15 أكتوبر 2025 03:33 م
أكثر الكلمات انتشاراً